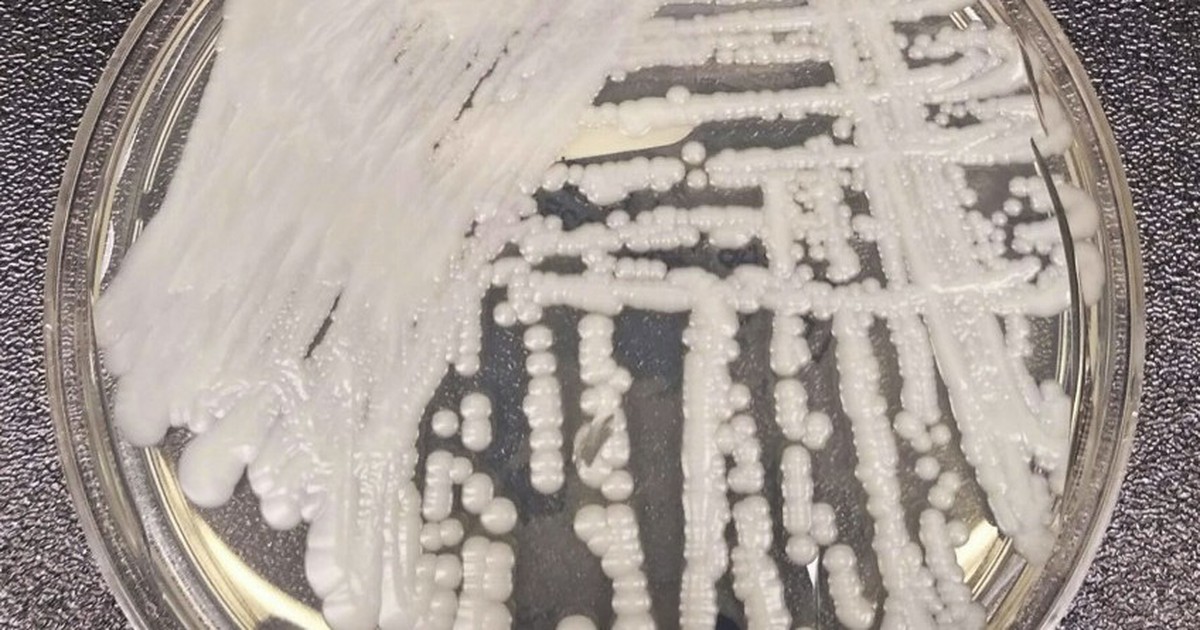
Siêu khuẩn kháng thuốc chết chóc tăng mạnh ở Mỹ trong thời gian dịch Covid-19

Nguy cơ với sức khỏe khi ăn phải thực phẩm nhiễm virus tả heo châu Phi
Virus gây bệnh tả heo châu Phi là chủng độc lực cao, lây lan rất nhanh. Không trực tiếp lây sang người nhưng thịt, thực phẩm chế biến từ heo bệnh tiềm ẩn nguy cơ với sức khỏe nếu tiêu thụ.